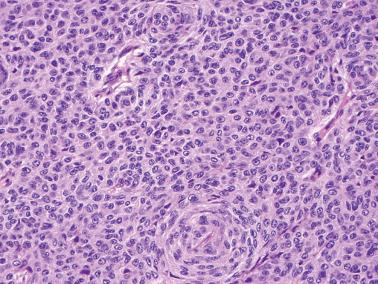
Fig. 14.33, Endometrioid adenocarcinoma with solid granulosa like pattern. A whorl at the bottom center is suggestive of abortive squamous differentiation, a helpful finding in many cases of this type.

Physical Address
304 North Cardinal St.
Dorchester Center, MA 02124
Most endometrioid tumors are epithelial and account for about 3% of all ovarian tumors. Endometrioid carcinomas account for 10–15% of ovarian carcinomas and at least 50% of stage I carcinomas. Endometrioid stromal sarcomas, mesodermal adenosarcomas, and malignant mesodermal mixed tumors are considered under separate headings.
Benign endometrioid tumors are mostly adenofibromas or cystadenofibromas; cystadenomas are uncommon but probably underdiagnosed. Borderline endometrioid tumors may be cystic or adenofibromatous, more often the latter.
Malignant endometrioid tumors of the ovary closely resemble their more common endometrial counterparts, whereas their benign counterparts lack an endometrial counterpart except for rare tumors that resemble an endometrial polyp.
Although some regard endometriosis as a neoplasm we do not (despite a monoclonal X-chromosome inactivation pattern in some endometriotic cysts). Endometriosis and neoplasms derived from it are considered in Chapter 19 .
Because of the close resemblance of serous and endometrioid cell types, particularly in benign neoplasms, the proportion of benign ovarian neoplasms that are endometrioid is difficult to determine.
Although the literature indicates that benign endometrioid tumors are much less common than their serous counterparts, adenocarcinomas arising from an adenofibroma (which are common) are usually endometrioid, suggesting that the adenofibroma is also endometrioid.
Additional evidence suggesting than an adenoma or cystadenoma is endometrioid is the presence of associated, often subtle, foci of endometriosis.
Benign, borderline, and malignant endometrioid epithelial tumors occur most commonly in the older reproductive and postmenopausal age groups (mean ages in the sixth decade).
Endometrioid tumors are associated with ipsilateral ovarian endometriosis or endometriosis elsewhere in the pelvis in 30–40% of cases. The most obvious examples are those found within an endometriotic cyst in which merging of neoplastic epithelium with typical or atypical endometriosis may be appreciable.
Endometrioid cystadenomas are usually indistinguishable from serous cystadenomas except for the more frequent presence of old or recent hemorrhage or associated endometriosis.
The lining epithelium is of endometrioid type, typically lacking cilia, and usually underlain by either compact cellular stroma or paucicellular fibrous stroma each usually lacking the arterioles of endometriotic stroma.
Cystadenomas are lined by cuboidal to columnar cells with bland cytologic features. The stroma ranges from paucicellular to highly cellular. The distinction between an endometrioid cystadenoma and an endometriotic cyst may be subjective and some lesions are a composite of the two.

Adenofibromas are either uniformly or predominantly solid whereas cystadenofibromas have a conspicuous cystic component. Rarely they form a mass in the wall of an endometriotic cyst. They are variable in size, cystadenofibromas being generally larger. The solid tissue is typically firm and white to tan.
Microscopic examination shows benign endometrioid glands (occasionally with mild atypia) and cysts dispersed in a usually paucicellular fibrous stroma; occasionally the latter is cellular with mitoses. Squamous metaplasia, typically morular, is common and may be associated with an edematous stroma that can erroneously suggest the desmoplastic stroma of a carcinoma.
Occasional adenofibromas and cystadenofibromas contain a few intraluminal polypoid projections which, particularly in conjunction with a cellular stroma if present, can raise concern for adenosarcoma (see latter heading).
One ovarian endometrioid cystadenofibroma was associated with identical tumor within a pelvic lymph node; an independent origin was favored ( ).





Borderline endometrioid cystadenomas typically have a polypoid or papillary lining with a low-power appearance often similar to that of cystic serous borderline tumors. They are distinguishable by the presence of atypical endometrioid glands covering the polypoid fronds and the frequent presence of squamous metaplasia. An association with endometriosis is often diagnostically helpful.
Endometrioid adenofibromas of borderline malignancy generally resemble their benign counterparts except for a usually higher gland:stroma ratio, greater architectural complexity, and, definitionally, cytologic atypia.
The neoplastic epithelium is usually only mildly to moderately atypical. A confluent growth pattern indicates an associated component of endometrioid adenocarcinoma that is usually low grade.
The presence of an occasional gland or even small clusters of glands with features of grade 1 endometrioid carcinoma is allowable in an endometrioid borderline tumor but should prompt judicious sampling.
Borderline endometrioid tumors with rare exceptions have been stage I and clinically benign.








The clinical manifestations of ovarian endometrioid carcinomas are broadly similar to those of other ovarian cancers, and may include elevated serum CA125 and rarely endocrine manifestations due to stromal luteinization. In contrast to serous carcinomas, most are stage I or occasionally stage II; rare stage III tumors are usually high grade.
Ovarian endometrioid carcinomas have a strong association with endometriosis, often arising within an endometriotic cyst or an endometriosis-associated adenofibroma.
The association of ovarian endometrioid carcinomas with endometriosis and/or endometrial endometrioid carcinomas, and the known response of endometriotic tissue to steroid hormones suggest that ovarian and endometrial endometrioid carcinomas may have similar risk factors.
About 15% of ovarian endometrioid carcinomas are associated with a synchronous, or rarely a metachronous, similar endometrial tumor; the frequency is higher in women <50 years of age and in those with HNPCC/Lynch syndrome. Similarly, found that ~50% of ovarian endometrioid carcinomas were associated with atypical endometrial hyperplasia.
Conventional criteria for diagnosing ovarian endometrioid carcinoma with spread to the uterus, endometrial endometrioid carcinoma with spread to the ovary, or independent primary tumors are listed in Tables 14.1–14.3 (also see Differential Diagnosis ). Clonality studies could also assist in this differential (see molecular features) but are rarely if ever needed.
|
|
|
Less commonly, an ovarian endometrioid carcinoma is associated with a synchronous similar tumor in the fallopian tube ( Chapter 11 ) or elsewhere in the pelvis ( Chapter 19 ).
Carcinomas range from soft, friable, or firm solid tumors to solid and cystic, to cystic tumors with a thin, soft irregular to papillary lining or a fungating intracystic mass. About 15% of stage I tumors are bilateral.
Some of the solid tumors may have obviously malignant gross characteristics whereas others may be grossly indistinguishable from an adenofibroma, the carcinoma being only identified on microscopic examination.
The cystic component may be recognizable as an endometriotic cyst or may have a nonspecific appearance but still contain chocolate-colored fluid.
Most tumors mimic the common subtypes of endometrial endometrioid carcinoma. Grade 1 tumors and the well-differentiated areas of higher-grade tumors have invasive glandular, cribriform, and less often villoglandular patterns composed of round, oval, or tubular glands lined by stratified, mostly mucin-poor epithelial cells. Invasion is typically expansile or confluent, infiltrative invasion being uncommon. Higher-grade tumors often have foci of solid growth.
The glands vary from medium-sized (most common) to tiny and ‘microfollicular’ to large and cystically dilated. The cysts may contain luminal eosinophilic mucin (that may resemble colloid) or less often a basophilic secretion. The lining of cystic glands may be flat. A minor component of columnar mucinous cells is not uncommon and discounted for classification purposes.
Morular or nonmorular squamous differentiation occurs in up to 50% of tumors, the former as rounded nests of small, immature but bland, often spindled, cells, the latter as foci of atypical to malignant squamous epithelium that may focally efface the associated glandular component. The squamous cells occasionally have clear cytoplasm. Keratin may elicit a foreign-body giant cell reaction within the tumor or on the peritoneum ( Chapter 20 ).
An association of the carcinoma with an endometrioid adenofibroma or endometriosis can be a diagnostically helpful clue to its primary nature.
Small endometrioid carcinomas may be an incidental microscopic finding within ovarian endometriosis either within or on the surface of the ovary. The association of surface tumor with endometriosis aids its distinction from an implant of an endometrial endometrioid carcinoma if one is present.
In cases in which carcinoma arises from an endometriotic cyst, the transition to carcinoma may be abrupt or there may be a spectrum from endometriosis to hyperplasia with atypia to carcinoma.
We grade endometrioid carcinomas using the WHO system for endometrial endometrioid carcinomas ( Chapter 8 ), although the prognostic significance of this grading system in the ovary has not been validated. Most tumors are grade 1 or 2; a minority are grade 3.
The stroma of endometrioid carcinomas varies from abundant to minimal; occasionally it may form intraglandular projections. Abundant stroma may be due to the presence of an associated adenofibroma from which the carcinoma has arisen. Occasionally the stroma is hyalinized and rarely may show osseous metaplasia. In some cases, the stroma is intensely cellular and may be focally mitotic.















Secretory pattern. Glandular lining cells contain subnuclear (and sometimes supranuclear) glycogen vacuoles resembling the glandular cells of an early secretory endometrium. In high-grade tumors, sub- and supranuclear clearing may be less evident but still focally appreciable. Solid clear cell foci may also be present
Sex cord-like foci . These elements, particularly when extensive, can lead to confusion with a sex cord–stromal tumor.
Small hollow tubular glands (sometimes in a lobular arrangement), solid tubules, or anastomosing cords can result in a sertoliform appearance. Tumor cells with pale cytoplasm can suggest a lipid-rich Sertoli cell tumor ( Chapter 16 ).
Solid areas sometimes punctuated by tubular, round, or tiny rosette-like glands may mimic the microfollicular pattern of an adult granulosa cell tumor. The solid areas may have cells with pale nuclei and even nuclear grooves mimicking the appearance of a granulosa cell tumor.
Diffuse, insular, or trabecular patterns may also mimic those patterns in sex cord tumors.
Luteinized stromal cells can mimic Leydig cells or the luteinized cells of a granulosa cell tumor, potentially increasing the likelihood of misdiagnosis.
Small nonvillous papillae. Some tumors have intraglandular buds of cells similar to those seen in the small nonvillous papillae of endometrial endometrioid carcinomas ( Chapter 8 ). Unlike the papillae of serous carcinoma, the cells usually have low-grade nuclear features like those in the rest of the tumor.
Transitional cell carcinoma (TCC)-like morphology. found this pattern in 14% of endometrioid carcinomas, which appeared as undulating ribbons or compact nests. Admixed squamous and typical endometrioid differentiation and absence of diffuse WT1, p53, and p16 expression indicate an endometrioid nature rather than a TCC-like pattern of serous carcinoma ( Chapter 13 ).
Corded and hyalinized (CHEC) and MELF pattern. These patterns of endometrial endometrioid carcinomas may occasionally occur in ovarian endometrioid carcinomas but are much less common than in the uterus.
Clear to pale cells of other types. Occasional tumors contain clear cells that differ in appearance from the secretory pattern, and when predominant may suggest clear cell carcinoma (CCC).
Clear cytoplasm varies from foamy to empty, likely reflecting the presence of glycogen, lipid, mucin, or hydropic change. The nuclei may be basilar, central, or apical. The clear cells are occasionally glycogenated squamous cells, as noted above.
Awareness that clear cells occur in endometrioid carcinomas and the absence of the tubulocystic, solid, and papillary patterns of CCC and immunohistochemical differences (see below) facilitate the diagnosis.
Spindle-shaped epithelial cells. These cells may merge with obvious squamous cells, suggesting abortive squamous differentiation. When conspicuous, a biphasic appearance may be imparted, potentially suggesting a malignant mesodermal mixed tumor (MMMT) (see Differential Diagnosis ).
Oxyphilic tumor cells. Occasional otherwise typical endometrioid adenocarcinomas contain tumor cells with abundant oxyphilic cytoplasm.
Ciliated cells. In these rare endometrioid adenocarcinomas, which usually have a cribriform pattern, most of the glandular lining cells bear cilia.
Undifferentiated carcinomatous component (dedifferentiated carcinoma) (see Mixed Carcinomas ).
Yolk sac tumor (YST). Rare otherwise typical endometrioid carcinomas are admixed with a component of YST ( Chapter 15 ).
Other findings that may be present include psammoma bodies, intraepithelial lymphocytes (that may reflect an association with mismatch repair (MMR) defects, see below), and in one case, Liesegang rings.

Immunostains are rarely necessary for diagnosis, but are helpful in distinguishing endometrioid carcinomas with sex cord-like patterns from a sex cord tumor (see below).
The typical immunoprofile of CK7+/EMA+/PAX8+/ER+/PR+ is similar to their endometrial counterparts, although found the ovarian endometrioid carcinomas are typically vimentin− in contrast to their endometrial counterparts.
Unlike serous carcinomas, there is usually negative or only focal positivity for WT1, p53, and p16. Caveats: some high-grade endometrioid carcinomas are diffusely p53+; found WT1 staining in 29% of endometrioid carcinomas.
As noted above, some ovarian endometrioid carcinomas are HNPCC/Lynch syndrome-related. (and ) found abnormal MMR status in ~14% of tumors, half of which were likely Lynch-related.
Most dMMR tumors show abnormal MLH1/PMS2 or abnormal MSH2/MSH6, with rare tumors showing only abnormal MSH6 or PMS2.
dMMR is associated with a younger age (usually <50 years), synchronous endometrial endometrioid carcinoma (with similar MMR profile) in up to 80% of cases, peritumoral lymphocytes, intratumoral stromal inflammation, tumor infiltrating lymphocytes, ≥20 CD8+ intraepithelial lymphocytes/hpf, and absence of ARID1A ( ).
Low-grade endometrioid carcinomas are strongly associated with CTNNB1, PTEN , KRAS, and PIK3CA mutations, and have high levels of microsatellite instability. found that PTEN mutations are less frequent in low-grade ovarian endometrioid carcinomas than in their endometrial counterparts (17% vs 67%) whereas CTNNB1 mutations were more common in the ovarian tumors (53% vs 28%).
found KRAS mutations in 29% of endometriosis-associated low-grade endometrioid carcinomas but in only 3% of those without this association. In another study, found that abnormal β-catenin expression correlated with cyclin D1 overexpression but was inversely related to KRAS mutation.
found mutations in exon 3 of the β-catenin gene in 60% of endometriosis-associated endometrioid carcinomas, in 52% of coexistent nonatypical endometriosis, and in 72% of coexistent atypical endometriosis. The same PIK3CA mutations in the tumors were present in the coexistent typical/atypical endometriosis.
Studies involving loss of heterozygosity (LOH), microsatellite instability, the mutations noted above, ß-catenin expression, and gene expression profiling may help distinguish synchronous primary ovarian and endometrial endometrioid carcinomas from a single primary tumor with metastases. Different genetic abnormalities, however, may reflect tumor heterogeneity rather than synchronous primary tumors.
Recent studies have found common clonality between some synchronous ovarian and endometrial endometrioid carcinomas, using mitochondrial DNA genotyping and using massively parallel sequencing and molecular inversion probe microarrays. Amador-Ortiz, Finkelstein et al., using profiling for KRAS point mutations and genotyping for LOH cancer-associated markers, found that of 15 synchronous tumors, 9 were independent primaries and 6 were metastatic.
found a low rate of POLE mutations (4.5%), predominantly in low-grade tumors, findings contrasting with those in their endometrial counterparts.
found that POLE -mutated tumors (that accounted for 10% of their endometrioid carcinomas) and MMR-abnormal tumors (8% of them) had excellent survival whereas p53-abnormal tumors had significantly higher rates of recurrence and death, findings that were independent of tumor grade and stage.
A variety of ovarian tumors other than endometrioid carcinomas may have an endometrioid-like glandular pattern ( Appendix 2 ). The most important of these differentials are discussed here but some elsewhere.
Serous and mucinous carcinomas ( Chapter 13 ).
Serous borderline tumor (SBT). Occasional endometrioid carcinomas with prominent cystic and papillary patterns and bland nuclear features can be confused with SBTs. Helpful findings in such cases included at least tiny foci of typical endometrioid carcinoma, squamous elements, associated endometriosis, and absent or only focal staining for WT1.
CCC.
CCC is in the differential of endometrioid carcinomas with clear cells, including those of secretory type, and occasional endometrioid carcinomas with cystically dilated glands. Unlike CCCs, endometrioid carcinomas contain columnar cells and the nature of the associated tumor generally facilitates the diagnosis.
Unlike CCCs, papillae with hyalinized cores and hobnail cells are rare in endometrioid carcinomas.
The columnar cells with sub- and supranuclear vacuoles of secretory carcinomas differ from the polygonal cells and more diffuse cytoplasmic clarity of CCCs.
Squamous elements and an ER+/PR+/napsin A−/HNF− profile indicate endometrioid carcinoma (caveat: rare tumors may be napsin A+ or HNF+, but with usually only focal staining).
Complicating this differential are rare bona fide mixed endometrioid-CCCs (see Mixed Carcinomas ) that contain discrete foci of each tumor type.
Metastatic endometrial carcinoma from the uterine corpus.
Features that favor synchronous primary neoplasia of each organ vs metastasis from one organ to the other are listed in Appendix 3 , Appendix 4 , Appendix 5 . Vimentin positivity favors an endometrial origin ( ). As noted above, molecular studies may also aid in this assessment but are rarely needed.
The usual excellent prognosis when tumor is confined to both organs favors independent primaries in most cases. The major prognostic determinant in such cases is the grade and depth of myoinvasion by the endometrial tumor.
Metastatic endocervical adenocarcinoma ( Chapter 18 ). These tumors typically have glands that architecturally resemble those of endometrioid carcinomas but are lined by cells with the amphophilic cytoplasm that is typical of most endocervical adenocarcinomas. Of course the known status of the cervix may play a crucial role. The presence of HPV and p16 positivity helps establish the diagnosis.
Extragenital metastatic carcinomas, particularly those arising in the intestine ( Chapter 18 ).
MMMT (vs endometrioid carcinoma with spindle cells) (see below).
Brenner tumor (vs endometrioid adenofibroma with morules). Brenner tumors lack the typical endometrioid glands of adenofibromas and the morules of the latter often show focal unequivocal squamous differentiation. Conspicuous nuclear grooves strongly favor Brenner tumor.
Sex cord–stromal tumors (vs endometrioid carcinomas with sex cord-like foci).
Bilaterality, associated endometriosis, foci of typical endometrioid carcinoma, luminal mucin, squamous differentiation, and an adenofibromatous component help establish a diagnosis of endometrioid carcinoma.
An EMA+/CK7+/inhibin−/calretinin−/SF1−/WT1− immunoprofile indicates endometrioid carcinoma. However, the epithelial elements of endometrioid carcinomas can rarely be inhibin+, and any non-neoplastic luteinized stromal cells will be inhibin+ and/or calretinin+.
Endometrioid-like YST ( Chapter 15 ).
Features favoring or establishing this diagnosis include an age <30 years, the presence of more common patterns of YST, and an AFP+/glycipan3+/EMA−/CK7− immunoprofile.
This differential is complicated by the rare YST arising within an endometrioid carcinoma. In such cases, the patient is usually older and features diagnostic of endometrioid carcinoma are also present. Additionally, in most such cases the two components are usually distinct rather than intermixed.
Ovarian tumor of probable wolffian origin ( Chapter 17 ).
These tumors, in contrast to endometrioid carcinomas, are devoid of luminal mucin and squamous differentiation. Other characteristic patterns of endometrioid carcinomas or wolffian tumors are usually present.
Positivity for EMA strongly favors a diagnosis of endometrioid carcinoma.
Ovarian ependymoma ( Chapter 15 ). Features confirming this diagnosis include perivascular pseudorosettes, occasional true rosettes, and basal fibrillary GFAP+ cytoplasm.
Most tumors are stage I. The 5-year survival rates in one study were 78% (stage I), 63% (II), 24% (III), and 6% (IV). More recently, found 10-year DFSs and PFSs of 94% and 96% in low-stage (I and II) tumors . Even stage III and poorly differentiated endometrioid carcinomas have a better prognosis than serous carcinomas.
found that patients with endometriosis-associated (vs endometriosis-unassociated) ovarian endometrioid carcinomas were younger and had tumors of lower stage and grade but no differences in survival.
Rare endometrioid carcinomas with a more malignant component (undifferentiated carcinoma, YST) have a prognosis more like that of the more aggressive component.
These tumors (MMMTs), also known as carcinosarcomas, account for <1% of all ovarian cancers. Seventy-five percent occur in the sixth to eighth decades; rare tumors occur in those <40 years of age. The presentation is usually that of an adnexal mass; rare tumors have been associated with an increased level of serum AFP. Occasional tumors have been associated with BRCA mutations or HNPCC/Lynch syndrome.
Occasional ovarian serous and undifferentiated carcinomas have recurred as MMMTs. In some cases the serous carcinomas and the MMMT have identical p53 mutations, suggesting unsampled sarcoma in the primary or transformation in the metastatic tumor.
MMMTs are typically large, predominantly solid or cystic, and are commonly necrotic and hemorrhagic. Occasional tumors arise within an endometriotic cyst. About one-third of tumors are bilateral if tumors of all stages are included.

The tumors resemble their endometrial counterparts ( Chapter 9 ). The various epithelial and sarcomatous components and their relative proportions can produce a highly variable appearance.
Although the two components are typically at least focally admixed, thorough sampling may be required to identify them in predominantly carcinomatous or sarcomatous tumors. Immunostains may be helpful in distinguishing sarcomatoid carcinoma from true sarcoma but are rarely needed.
Occasional tumors that are mostly carcinoma with only small foci of sarcoma are appropriately reported as ‘poorly differentiated carcinoma (specify type) with focal transformation to MMMT’.
The carcinomatous component is most commonly serous, endometrioid, or undifferentiated; glandular neoplasia that is difficult to classify as to cell type is not uncommon. Squamous or clear cell carcinoma is less common, and mucinous carcinoma is rare.
Homologous tumors account for half the cases and typically have a high-grade, predominantly spindle cell, nonspecific sarcomatous component. Heterologous tumors contain one or more of: rhabdomyoblasts, chondrosarcoma, osteosarcoma, bone, or fat, usually in addition to homologous sarcoma.
PASD+ hyaline bodies are a common but nonspecific feature, especially in the sarcomatous component.
Rarely, the presence of non-mesodermal tissues can suggest a germ cell tumor (‘teratoid carcinosarcoma’), including glial and neuronal tissue and foci resembling PNET, YST, hepatic-type cells, foci of trophoblastic differentiation, and malignant melanoma.





Undifferentiated carcinoma. Recognition of a minor sarcomatous component within an undifferentiated carcinoma (resulting in a diagnosis of MMMT) can be difficult.
Endometrioid carcinomas with spindle cells and other sarcomatoid carcinomas.
Compared to MMMTs, these tumors typically have spindle cells that blend with the obvious carcinomatous elements in contrast to the sharp demarcation between the two components that is usually seen, at least focally, in MMMTs. Additionally, there is a more heterogenous random admixture of the carcinomatous and sarcomatous components in MMMT.
Endometrioid carcinomas with spindle cells usually have a lower-grade epithelial component than in MMMTs.
Serous carcinoma with a pseudosarcomatous stromal reaction. This finding may raise concern for an MMMT in a small biopsy specimen but the reactive nature of the stroma will be more apparent on thorough sampling
Surface epithelial carcinoma with sarcomatous mural nodule. Such tumors are otherwise typical mucinous, serous, or clear cell carcinomas that contain a sarcomatous nodule (rhabdomyosarcoma, fibrosarcoma, or leiomyosarcoma). They lack the usual extensive admixture of carcinomatous and sarcomatous elements of MMMTs.
Immature teratomas ( Chapter 15 ). Features favoring or indicating immature teratoma include an age <30 years, elements derived from all three germ layers, a predominant component of immature neuroectodermal tissue, an embryonal (vs carcinomatous) epithelial component, and immature or mature (vs malignant) cartilage.
Moderately and poorly differentiated SLCTs with or without heterologous elements ( Chapter 16 ).
These tumors usually occur in young women who may be virilized, and usually contain foci of overt SLCT.
Surface epithelial-like elements, if present, are mucinous (which usually appears benign or borderline). Retiform Sertoli elements should not be misinterpreted as a serous component.
Stromal elements may be spindled and mitotic but are usually less pleomorphic than the sarcomatous component of an MMMT.
An inhibin+/calretinin+/EMA− immunoprofile strongly favors a SLCT, whereas the converse favors a MMMT.
Endometrioid stromal sarcomas containing sex cord-like elements. These tumors are generally lower grade than MMMTs and their sex cord-like elements resemble the sex cord components of sex cord–stromal tumors rather than the carcinomatous component of MMMTs. Typical tongue-like growth is often seen in the extraovarian foci of disease that are often present.
In 90% of cases there is extraovarian spread at diagnosis. The metastatic deposits most commonly contain both carcinomatous and sarcomatous components but may be purely one or the other.
The prognosis is poor. found that 70% of patients died of disease after a median follow-up of 29 months; a sarcomatous component in metastatic tumor was an adverse prognostic parameter. Using SEER data, found survival rates for stage I and IIIc tumors of 65% and 18%, respectively.
Most of these tumors occur in the fifth and sixth decades. All of them have been unilateral. They may be predominantly solid or solid and cystic; some also have an exophytic surface component and rare tumors are entirely exophytic. Occasional tumors have arisen within an endometriotic cyst.
Low-power examination shows the characteristic biphasic pattern of uterine adenosarcoma ( Chapter 9 ). Glands, many of which may be cystic, are often surrounded by periglandular condensation of the sarcomatous stroma, which often forms intraglandular polypoid or papillary projections. Narrow cleft-like spaces may be prominent.
The glandular epithelium is usually endometrioid or serous, but occasionally is focally mucinous or of clear cell type. The epithelium usually has a benign appearance, but may focally exhibit varying degrees of nuclear atypicality, including foci of intraepithelial carcinoma.
Expansile overgrowth of atypical epithelium indicates the rare development of an adenocarcinoma within an adenosarcoma. We distinguish such tumors from a MMMT because it is likely that their behavior will be more similar to that of typical adenosarcoma than a MMMT.
The sarcomatous component usually resembles an ESS or a grade 1 or 2 fibrosarcoma. Hypocellular and fibrotic or edematous areas may have a deceptively benign appearance; rarely the sarcomatous cells appear deciduoid. The mitotic rate of the stromal cells ranges from 2 to >40 mf/10 hpf.
found sarcomatous overgrowth (SO), sex cord-like (or sex cord) elements, and heterologous stromal elements in 30%, 15%, and 12.5% of cases, respectively.
SO is sometimes overdiagnosed. In typical adenosarcoma the sarcomatous stroma may predominate, but there is still an intimate admixture of the two components. In contrast, a diagnosis of SO requires effacement of at least 25% of the tumor by a pure sarcoma, which is sometimes of higher grade than that of the associated adenosarcoma.
Rare findings have included overgrowth by a pattern resembling juvenile granulosa cell tumor possibly derived from sex cord elements within the tumor ( ) and focal neuroectodermal differentiation ( ).



Endometrioid adenofibroma and cystadenofibroma. Features favoring adenosarcoma include periglandular cuffing, prominent intraglandular stromal projections, more than minimal stromal nuclear atypicality, conspicuous mitotic activity, and heterologous elements. This differential diagnosis can be difficult in some cases (particularly because of stromal mitoses and polypoid projections in some endometrioid adenofibromas) and caution should be exercised in relying on only one feature.
Polypoid endometriosis ( Chapter 19 ). This lesion lacks the prominent intraglandular polypoid projections of cellular stroma and the low-grade sarcomatous stroma characteristic of adenosarcoma.
MMMTs. In contrast to adenosarcomas, these tumors have an exclusively carcinomatous epithelial component and a high-grade sarcomatous component.
Ovarian adenosarcomas are more aggressive than their uterine counterparts. About a third of tumors have spread beyond the ovary at the time of presentation. found that of 16 patients with follow-up, 3 died of tumor and 8 were alive after one or two recurrences.
With very rare exceptions, all of the reported endometrioid stromal sarcomas of ovarian origin have been low-grade (LGESSs). Coverage here is confined to LGESSs other than brief mention of high-grade endometrioid stroma sarcoma (HGESSs) in the differential diagnosis. A report of a large series of extrauterine ovarian and nonovarian LGESSs ( ) is considered in Chapter 19 (Endometriosis-Associated Tumors).
LGESSs occur over a wide age range (11–76 years; mean, 56 years) and usually present as an ovarian mass. There is a frequent association with endometriosis.
LGESSs are unilateral in 80% of cases, have a mean diameter of 9.5 cm, and may be solid, solid and cystic, or cystic. The solid foci have a tan to yellow sectioned surface, often with focal necrosis or hemorrhage and intracystic blood.
Microscopy reveals a typically diffuse proliferation of small cells interspersed with arterioles. The cells have scanty cytoplasm with bland round to oval nuclei resembling to varying degrees endometrial stromal cells. One series ( ) found from <1 to 17 mf/10hpf; most tumors had <5 mf/10hpf.
The tumors often lack infiltrative borders of uterine LGESSs, although extraovarian tumor, if present, may be more infiltrative.
Half of the tumors contain fibromatous areas that may predominate and exhibit a storiform pattern. Less common findings include sex cord-like elements (as in uterine LGESSs, Chapter 9 ), foci of smooth muscle, and rare benign endometrioid glands that may be entrapped endometriotic glands or endometrioid glandular differentiation (as in their uterine counterparts).
Other findings may include foci of hemorrhage, infarct-type necrosis, foam cells, hyaline plaques, and extensive collagen deposition. found an intimate association with endometriosis in 60% of their cases.
Reticulin staining discloses a dense pericellular reticulin pattern, and lipid stains may reveal numerous fine droplets in the tumor cells and the foam cells.
The tumor cells are typically CD10+/ER+/PR+. The characteristic JAZF1 gene rearrangements of uterine LGESSs ( Chapter 9 ) also occur in ovarian LGESSs.


High-grade endometrioid stromal sarcoma of ovary (HGESS). A category of HGESS is present in the 2014 WHO classification of ovarian tumors to provide for ovarian examples of HGESS although none had been reported at the time of the formulation of the classification.
In 2015 included one ovarian HGESS as a control in a study of ovarian hypercalcemic small cell carcinomas.
In 2017, briefly reported an ovarian HGESS with features similar to uterine HGESSs including YWHAE and NUTM2B rearrangements and an aggressive clinical course.
Metastatic uterine ESS.
Up to 30% of ovarian ESSs are associated with a synchronous or metachronous uterine ESS that in some cases was diagnosed years earlier. Many of the ovarian tumors are probably metastatic from the uterine tumors, although others may be independent primaries.
In this differential, knowledge of the status of the uterus is obviously crucial. General features that aid in differentiating primary and secondary ovarian tumors are also helpful ( Chapter 18 ), i.e., the relative sizes of the uterine and ovarian tumors, their extent, the unilaterality or bilaterality of the ovarian tumors, and the presence or absence of vascular invasion.
The slides from any previous hysterectomy specimen should ideally be reviewed, particularly if they have shown any form of mesenchymal neoplasm, even a ‘fibroid’. In the absence of the latter, it may be impossible to exclude spread from a uterine ESS without evaluation of the uterus.
regard ESSs as primary in the ovary only when they are confined to this site and the uterus is free of tumor. Continuity with ovarian endometriosis is also strong evidence of ovarian origin.
Adult granulosa cell tumor and other sex cord tumors.
Features favoring ESS include a lack of endocrine manifestations, bilaterality, numerous arterioles, reticulin fibrils investing single cells, a tongue-like pattern of infiltration (particularly in extraovarian tumor), lack of nuclear grooves, an inhibin−/calretinin− profile, and association with endometriosis.
Sex cord-like elements, if present in an ESS, are usually a minor component and usually lack the pale grooved nuclei of granulosa cells and the distinctive patterns of the Sertoli cell components of a sex cord–stromal cell tumor.
MMMT (vs ovarian ESSs with sex cord-like differentiation) (see MMMT, Differential Diagnosis ).
Stromal hyperplasia. This lesion is rarely associated with significant ovarian enlargement and lacks the arteriolar content and the resemblance to endometrial stroma of ovarian ESSs.
Cellular fibroma and thecoma. Estrogenic manifestations and the typical tinctorial properties of the cytoplasm of thecoma cells are lacking in ovarian ESSs (see Chapter 16 ). Fibromas of usual and cellular type lack endometrial–stromal differentiation and the numerous arterioles of ESSs, and unlike ESSs, are usually CD10−.
Other small cell malignant tumors that may involve the ovary ( Appendix 15 ). Other than their content of small cells, these tumors (all discussed elsewhere) have significant microscopic differences, including usually a greater degree of nuclear atypia than ovarian ESSs.
Ovarian ESSs often have an indolent course even though as many as two-thirds of them are stage II or III; rare cases are stage IV.
found that of 21 patients with follow-up, 10 were free of disease at 4–21 years, 6 were alive with disease at 2–17 years, and 5 died of disease at 2–17 years.
Benign clear cell tumors are rare; cystadenomas are close to unheard of and adenofibromas only slightly more common. A cystic tumor that has cells recognizable as enabling placement in the clear cell group will almost always result in the diagnosis of cystic clear cell carcinoma. If the atypical proliferation is limited, a comment on a likely good prognosis is warranted.
Borderline clear cell tumors, almost all of which are adenofibromatous, account for <1% of ovarian borderline tumors.
CCCs account for 5–10% of surface epithelial carcinomas in the United States but for 20% of the latter in Japan. Almost 90% of CCCs occur in the fifth to seventh decades and 10% in the fourth decade; the mean age is 55 years (vs 63 years for serous carcinomas). The majority of tumors are stage I.
CCCs are associated with ovarian and pelvic endometriosis in at least 50% of cases, representing the highest association among all epithelial cancers. Many CCCs arise from an endometriotic cyst and less commonly arise from a clear cell adenofibroma of borderline malignancy. Less common associations include HNPCC/Lynch syndrome, paraneoplastic hypercalcemia, and thromboembolic complications.
Clear cell adenofibromas (benign or borderline) have a nonspecific mostly solid appearance, but some tumors have tiny cysts or larger cysts imparting a honeycomb sectioned surface.
CCCs are typically unilocular or less often multilocular cysts with polypoid intraluminal masses to nonspecific solid or solid and cystic masses. Some cysts may be grossly recognizable as endometriotic. CCCs with an adenofibromatous component may exhibit the gross features of the latter, as noted above.
The cyst lumens may contain serous or mucinous fluid. Endometriotic cyst-associated tumors may have chocolate-colored fluid with patchy brown discoloration of the cyst lining.
Benign and borderline clear cell tumors are almost invariably unilateral; CCCs are bilateral in ~3% of stage 1 cases.


These tumors are almost always adenofibromatous and must be thoroughly sampled to exclude foci diagnostic of CCC that may be limited in amount.
Clear cell adenofibromas contain glands, often cystically dilated, lined by benign clear or more typically flattened cells (see below). These tumors are rare as most clear cell adenofibromatous tumors have enough atypia to warrant classifying them as borderline.
Borderline adenofibromas contain atypical epithelium that is usually of clear or hobnail type. If carcinomatous epithelium without invasion is present, the tumor is a borderline adenofibroma but such a tumor should be thoroughly sectioned to exclude invasion, especially if the epithelial proliferation is striking. Closely packed glands without stroma or only minimal intervening stroma should raise concern for CCC.




Become a Clinical Tree membership for Full access and enjoy Unlimited articles
If you are a member. Log in here